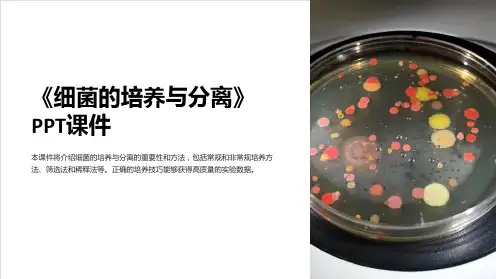

微生物检验第九章 细菌的培养与分离技术讲义
- 格式:doc
- 大小:208.50 KB
- 文档页数:4





细菌的培养与分离技术一、基本条件(一)细菌实验室细菌实验室是进行细菌学实验的场所,标本的接种、培养、分离、鉴定及药敏试验等工作都要在此完成。
所以细菌实验室应该符合一定的条件。
应执行中华人民共和国卫行业标准中的微生物和生物医学实验室生物安全通过准则。
1.细菌室必须安装严密的门窗,以防室内环境受到外界的污染。
且室内禁用风扇,避免细菌的播散。
2.细菌室必须安装供空气消毒的紫外线灯,置于操作台上面1m处,每天开始工作前照射20min。
对其消毒效果要定期检查,及时更换失效的灯管。
3.室内应备有消毒剂,用于试验中发生菌液洒溅时的及时消毒处理。
同时还应备有供工作人员浸手用的盛有消毒剂的水盆、肥皂及自来水源等,应安装冲眼器。
4.室内操作台须每日用消毒剂擦洗,地面至少一周用消毒剂擦洗1次。
5.对接收的标本、无菌器具、用过的物品等应明显分开并放在指定位置。
对用过的物品及时进行灭菌处理。
6.细菌室根据当地的气温特点,安装空调机,以适合细菌实验工作。
同时室内应设置必要的消防设备。
7.细菌室必须安装生物安全柜,工作人员应在柜内处理标本及病原微生物。
(二)无菌实验室无菌实验室是细菌实验室内用于无菌操作的小室,其内部装饰、消毒条件要求更严格。
1.无菌室应完全封闭,人员出入应有两道门,其间应隔有缓冲区。
2.用前应以紫外线消毒30min,定期用乳酸或甲醛熏蒸,彻底消毒。
3.在无菌室中一般仅限于分装无菌的培养基及传染性强的细菌的接种,不进行有菌标本的分离及其他操作。
4.无菌室内应仅限操作人员进入,而且进入无菌室应着隔离衣和专用鞋,操作时戴口罩,随时保证室内的无菌状态。
5.无菌室应配备空调设备,保证不因室温而影响工作。
(三)基本设备和器具包括温箱、CO2培养箱、厌氧培养设备;显微镜、高压蒸气灭菌器、干烤箱、冰箱和冷藏柜、接种环和接种针、pH计;火焰灯或酒精灯;平皿、试管、吸管等玻璃器皿,以及离心机、天平等。
二、细菌的接种与分离技术为了从临床标本中分离出病原菌并进行准确鉴定,除选择好合适的培养基外,还要根据待检标本的来源、培养目的及所使用培养基的性状,采用不同的接种方法。

第九章细菌的培养与分离技术本章内容一、基本条件二、细菌的接种与分离技术三、细菌培养的方法四、细菌的生长现象五、细菌L 型的检查基本条件(一)细菌实验室:生物安全柜。
(二)无菌实验室(三)基本设备和器具:温箱、 CO2培养箱、厌氧培养设备;显微镜;高压蒸汽灭菌器、干烤箱;接种环和接种针;火焰灯或酒精灯;平皿、试管、吸管等玻璃器皿,以及离心机、天平等。
细菌的接种与分离技术平板划线分离法:分散生长,各自形成菌落。
连续划线法:杂菌不多。
分区划线法:杂菌多。
斜面接种法:单个菌落纯培养、保存菌种或观察细菌的某些特性。
液体接种法:多用于一些液体生化试验管的接种。
穿刺接种法:半固体培养基,接种针。
倾注平板法:测定牛乳、饮水和尿液等标本细菌数。
将标本适当稀释后,取一定量加入已灭菌的平皿内,再倾入已溶化并冷却至 45℃左右的定量培养基,混匀,待凝固后倒置、培养。
涂布接种法:常用于纸片法药物敏感性测定,也可用于被检标本中的细菌计数。
细菌的培养方法培养条件:根据临床初步诊断及待检细菌的种类,选用不同环境条件进行培养。
细菌的生长现象分离培养基上菌落的生长现象观察菌落的大小、形状、突起、边缘、颜色、表面、透明度等。
血琼脂上的溶血:α溶血:菌落周围出现绿色环状,红细胞外形完整无缺。
β溶血:菌落周围形成一个完全清晰透明的环,红细胞溶解。
γ溶血:没有溶血,红细胞无溶解。
双环:菌落周围完全溶解的晕圈外有一个部分溶血的第二圆圈。
气味液体培养基中的生长现象肉汤培养基的混浊度、沉淀、菌膜,气味和色素等。
细菌数量达106~ 107CFU/ml,培养肉汤才见混浊。
血液培养的检查和传代培养:肉眼观察其生长现象,如溶血、产生气体或混浊度等。
半固体培养基中细菌的动力有动力的细菌除了在穿刺接种的穿刺线上生长外,在穿刺线的两侧均可见混浊或细菌生长的小菌落。
细菌 L 型的检查1.标本采集:无杂菌污染的组织或体液标本应加 20%蔗糖无菌溶液保持高渗;血液标本应接种高渗肉汤增菌培养。

精心整理细菌的培养与分离技术一、基本条件二、细菌的接种与分离技术三、细菌培养的方法四、细菌的生长现象五、细菌L 型的检查一、基本条件(一)细菌实验室1.2.3. 4. 5.菌处理。
6.7. 1. 2. 3.4. 5. pH二、细菌的接种与分离技术(一)平板划线分离法在被检标本中,常混杂有多种细菌,平板划线分离法可使这多种细菌在培养基表面分散生长,各自形成菌落,以便根据菌落的形态及特征,挑选单个菌落进行纯培养。
常用的平板划线分离法有以下两种: 1.连续划线分离法杂菌不多的标本。
2.分区划线分离法杂菌量较多的标本。
(二)斜面接种法该法主要用于单个菌落的纯培养、保存菌种或观察细菌的某些特性。
(三)液体接种法多用于一些液体生化试验管的接种。
(四)穿刺接种法此法主要用于半固体培养基、明胶及双糖管的接种。
(五)倾注平板法测定牛乳、饮水和尿液等标本细菌数时常用此方法。
(六)涂布接种法常用于纸片法药物敏感性测定,也可用于被检标本中的细菌计数。
三、细菌培养的方法根据临床初步诊断及待检细菌的种类,可选用不同环境条件进行培养。
常用的有需氧培养法、二氧化碳培培养瓶置35℃6~18h后,用肉眼观察其生长现象,如:溶血、产生气体或混浊度等。
应每天肉眼检查细菌生长情况,若为生长阳性应做进一步的分离鉴定和药敏;若为生长阴性,应孵至第7天弃去。
有些细菌如奈瑟菌属和嗜血杆菌属的菌株,心杆菌属、放线杆菌属的细菌都需要较长时间培养。
血培养孵育24h后,肉眼观察阴性的血培养瓶,一般不需做常规显微镜检查,因培养物中有105菌落形成单位CFU/ml,才能通过革兰染色检出细菌。
(三)细菌在半固体培养基中的生长现象半固体培养基用于观察细菌的动力,有动力的细菌除了在穿刺接种的穿刺线上生长外,在穿刺线的两侧均可见有混浊或细菌生长的小菌落。
五、细菌L型的检查细菌L型是细胞壁缺陷从而生物学特性发生改变的一种细菌,是细菌在不利环境下种系保存的一种形式。

细菌的培养与分离技术一、基本条件(一)细菌实验室细菌实验室是进行细菌学实验的场所,标本的接种、培养、分离、鉴定及药敏试验等工作都要在此完成。
所以细菌实验室应该符合一定的条件。
应执行中华人民共和国卫行业标准中的微生物和生物医学实验室生物安全通过准则。
1.细菌室必须安装严密的门窗,以防室内环境受到外界的污染。
且室内禁用风扇,避免细菌的播散。
2.细菌室必须安装供空气消毒的紫外线灯,置于操作台上面1m处,每天开始工作前照射20min。
对其消毒效果要定期检查,及时更换失效的灯管。
3.室内应备有消毒剂,用于试验中发生菌液洒溅时的及时消毒处理。
同时还应备有供工作人员浸手用的盛有消毒剂的水盆、肥皂及自来水源等,应安装冲眼器。
4.室内操作台须每日用消毒剂擦洗,地面至少一周用消毒剂擦洗1次。
5.对接收的标本、无菌器具、用过的物品等应明显分开并放在指定位置。
对用过的物品及时进行灭菌处理。
6.细菌室根据当地的气温特点,安装空调机,以适合细菌实验工作。
同时室内应设置必要的消防设备。
7.细菌室必须安装生物安全柜,工作人员应在柜内处理标本及病原微生物。
(二)无菌实验室无菌实验室是细菌实验室内用于无菌操作的小室,其内部装饰、消毒条件要求更严格。
1.无菌室应完全封闭,人员出入应有两道门,其间应隔有缓冲区。
2.用前应以紫外线消毒30min,定期用乳酸或甲醛熏蒸,彻底消毒。
3.在无菌室中一般仅限于分装无菌的培养基及传染性强的细菌的接种,不进行有菌标本的分离及其他操作。
4.无菌室内应仅限操作人员进入,而且进入无菌室应着隔离衣和专用鞋,操作时戴口罩,随时保证室内的无菌状态。
5.无菌室应配备空调设备,保证不因室温而影响工作。
(三)基本设备和器具包括温箱、CO2培养箱、厌氧培养设备;显微镜、高压蒸气灭菌器、干烤箱、冰箱和冷藏柜、接种环和接种针、pH计;火焰灯或酒精灯;平皿、试管、吸管等玻璃器皿,以及离心机、天平等。
二、细菌的接种与分离技术为了从临床标本中分离出病原菌并进行准确鉴定,除选择好合适的培养基外,还要根据待检标本的来源、培养目的及所使用培养基的性状,采用不同的接种方法。
第九章细菌的培养与分离技术
本章内容
一、基本条件
二、细菌的接种与分离技术
三、细菌培养的方法
四、细菌的生长现象
五、细菌L型的检查
基本条件
(一)细菌实验室:生物安全柜。
(二)无菌实验室
(三)基本设备和器具:温箱、CO2培养箱、厌氧培养设备;显微镜;高压蒸汽灭菌器、干烤箱;接种环和接种针;火焰灯或酒精灯;平皿、试管、吸管等玻璃器皿,以及离心机、天平等。
细菌的接种与分离技术
平板划线分离法:分散生长,各自形成菌落。
连续划线法:杂菌不多。
分区划线法:杂菌多。
斜面接种法:单个菌落纯培养、保存菌种或观察细菌的某些特性。
液体接种法:多用于一些液体生化试验管的接种。
穿刺接种法:半固体培养基,接种针。
倾注平板法:测定牛乳、饮水和尿液等标本细菌数。
将标本适当稀释后,取一定量加入已灭菌的平皿内,再倾入已溶化并冷却至45℃左右的定量培养基,混匀,待凝固后倒置、培养。
涂布接种法:常用于纸片法药物敏感性测定,也可用于被检标本中的细菌计数。
细菌的培养方法
培养条件:根据临床初步诊断及待检细菌的种类,选用不同环境条件进行培养。
细菌的生长现象
分离培养基上菌落的生长现象
观察菌落的大小、形状、突起、边缘、颜色、表面、透明度等。
血琼脂上的溶血:
α溶血:菌落周围出现绿色环状,红细胞外形完整无缺。
β溶血:菌落周围形成一个完全清晰透明的环,红细胞溶解。
γ溶血:没有溶血,红细胞无溶解。
双环:菌落周围完全溶解的晕圈外有一个部分溶血的第二圆圈。
气味
液体培养基中的生长现象
肉汤培养基的混浊度、沉淀、菌膜,气味和色素等。
细菌数量达106~107CFU/ml,培养肉汤才见混浊。
血液培养的检查和传代培养:肉眼观察其生长现象,如溶血、产生气体或混浊度等。
半固体培养基中细菌的动力
有动力的细菌除了在穿刺接种的穿刺线上生长外,在穿刺线的两侧均可见混浊或细菌生长的小菌落。
细菌L型的检查
1.标本采集:无杂菌污染的组织或体液标本应加20%蔗糖无菌溶液保持高渗;血液标本应接种高渗肉汤增菌培养。
2.分离培养:标本接种到高渗肉汤增菌培养1~7d,然后转种L型平板和血平板37℃培养2~7d。
3.生长现象:常有油煎蛋样菌落(典型L型菌落)、颗粒型菌落(G型)和丝状菌落(F型)三种类型。
平板分区划线的目的
A.使细菌获得充分的营养
B.减少细菌间的相互抑制
C.获得足够的单个菌落
D.利于细菌的大量生长
E.加快细菌的生长速度
『正确答案』C
『答案解析』平板划线分离法:分散生长,各自形成菌落。
连续划线法:杂菌不多。
分区划线法:杂菌多。
在临床细菌学检验中,含菌量较多的标本如粪便,接种方法适宜用
A.平板倾注培养法
B.平板连续划线法
C.平板分区划线法
D.斜面接种法
E.半固体穿刺接种法
『正确答案』C
『答案解析』对于含菌量较多的标本适宜用平板分区划线法。
关于倾注平板法,错误的是
A.可用于尿液、牛乳等标本的计数
B.所用培养基预先灭菌后溶化
C.先取一定量标本加入无菌平皿内,再加入培养基混匀
D.先取一定量标本与培养基混匀后,再倒入无菌平皿内
E.培养基温度以45℃左右为宜
『正确答案』D
『答案解析』倾注平板法应先取一定量标本加入无菌平皿内,再加入培养基混匀。
不属于细菌形态学观察的是
A.平板分区划线观察单个菌落
B.革兰染色观察细菌染色性
C.鞭毛染色观察细菌的动力
D.光镜观察细菌
E.暗视野显微镜观察细菌动力
『正确答案』A
『答案解析』平板分区划线观察单个菌落属于细菌生长现象,不是细菌形态学。
平板划线分离细菌成功的标志是
A.Ⅰ区和Ⅱ区不相连
B.有明显的三区划线
C.培养出单个菌落
D.不能划破培养基
E.不能有污染菌生长
『正确答案』C
『答案解析』平板划线分离细菌成功的标志是培养出单个菌落。
观察细菌动力最常使用
A.液体培养基
B.半固体培养基
C.固体平板培养基
D.固体斜面培养基
E.厌氧培养基
『正确答案』B
『答案解析』观察细菌动力最常使用半固体培养基。